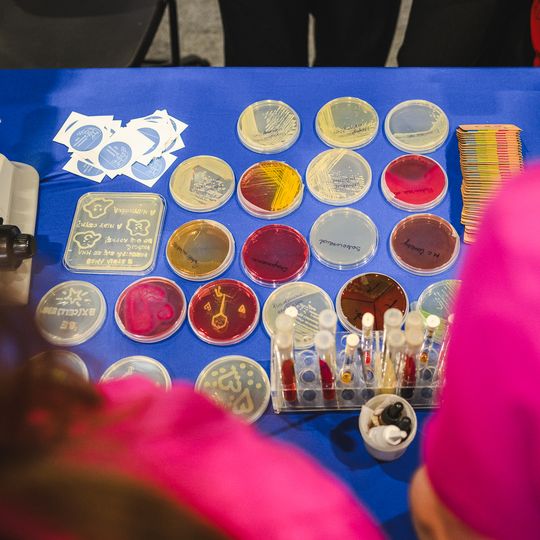
Dzień Otwarty GUMed 2026, Gdańsk

Szycie, leczenie i nauka. Zobacz, co działo się na Dniu Otwartym GUMed 2026!
Poczuj atmosferę studiów medycznych! Zobacz zdjęcia z warsztatów, pokazów i spotkań dla kandydatów na studentów Gdańskiego Uniwersytetu Medycznego. Sprawdź, co działo się podczas tego wyjątkowego wydarzenia.
Więcej: Dzień Otwarty GUMed 2026. Szyli, leczyli i poznawali uczelnię od kuchni
.png)

Napisz komentarz
Komentarze